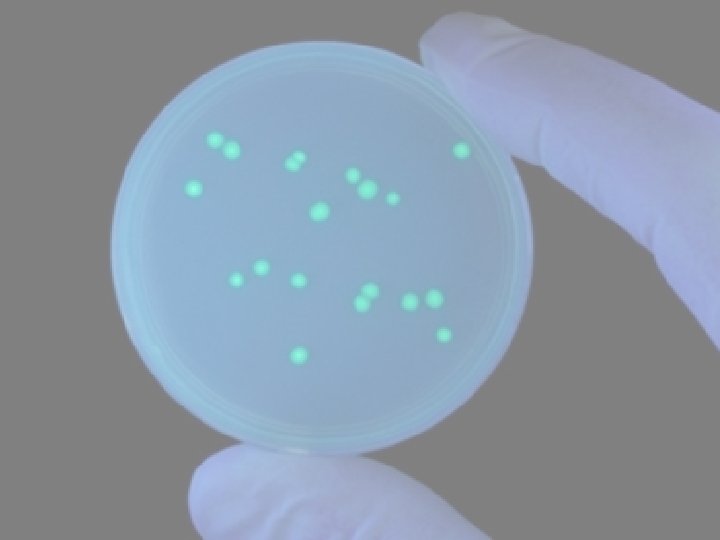
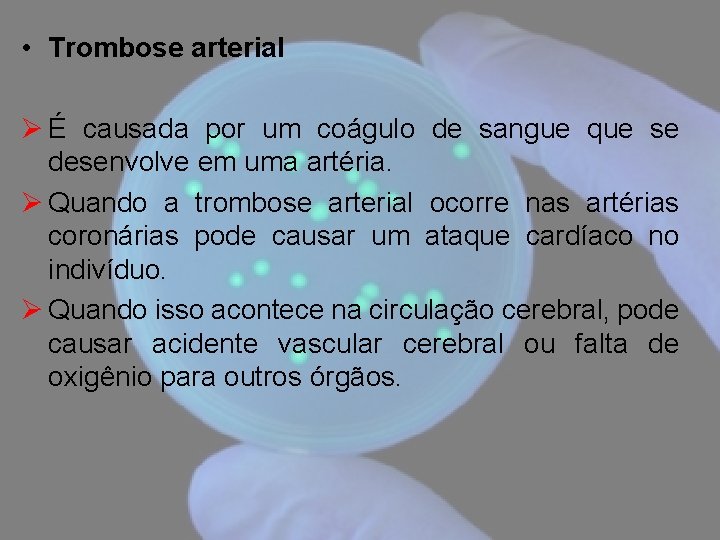
• Trombose arterial Ø É causada por um coágulo de sangue que se
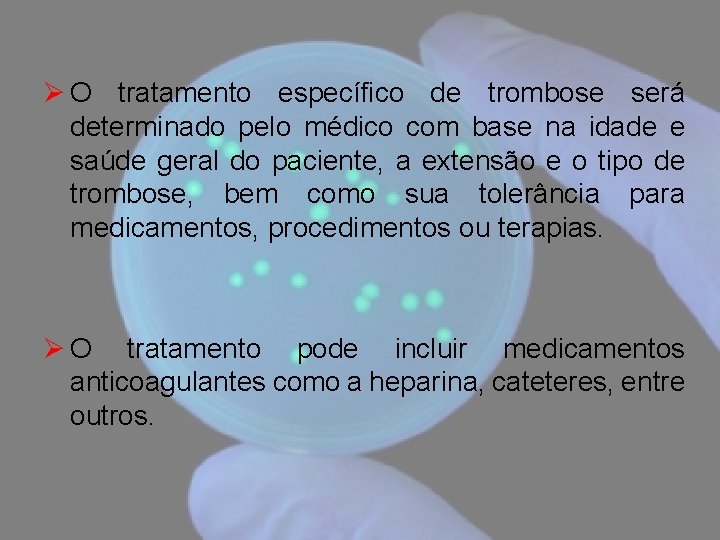
Ø O tratamento específico de trombose será determinado pelo médico com base na idade

Noes Patolgicas Enf Marlia M Varela O que

- Slides: 113
Noções Patológicas Enfª: Marília M. Varela
O que é patologia Ø Estudo das doenças Ø É através desta ciência que estudamos como os órgãos e tecidos de um organismo saudável, sob o ponto de vista anatômico e fisiológico, modificam-se em uma pessoa doente.
Ø É a ciência que estuda as causas doenças, os mecanismos que as produzem, as sedes e as alterações morfológicas e funcionais que apresentam. Ø A patologia é apenas uma parte de um todo que é a medicina. Ø O diagnóstico clínico, a prevenção, e a terapêutica das doenças não são objetos de estudo da patologia.
Saúde Ø Um estado de adaptação do organismo ao ambiente físico, psíquico ou social em que vive, em que o indivíduo sente-se bem (saúde subjetiva) e não apresenta sinais ou alterações orgânicas videntes (saúde objetiva).
Doença Ø É um estado de falta de adaptação ao ambiente físico, psíquico ou social, no qual o indivíduo sente-se mal (sintomas) e/ou apresenta alterações orgânicas evidenciáveis (sinais).
Adaptação do organismo às variações do meio ambiente Ø Variação do ambiente Provocam estímulos que geram respostas adaptativas. Quando os estímulos ultrapassam a capacidade adaptativa. . . passam a representar agressões ou causas externas de doenças.
Processos patológicos gerais Ø Lesão celular Ø Morte Celular Ø Inflamação Ø Neoplasia Aguda Crônica
Ø Lesão ou processo patológico é o conjunto de alterações morfológicas, moleculares e/ou funcionais que surgem nos tecidos após agressões. Ø As lesões são dinâmicas: começam, evoluem e tendem para a cura ou para a cronicidade.
As lesões celulares podem ser consideradas em dois grupos: Ø Lesão celular não-letal São aquelas compatíveis com a regulação do estado de normalidade após cessada a agressão; a letalidade ou não está frequentemente ligada à qualidade, à intensidade e à duração da agressão, bem como ao estado funcional ou tipo de célula atingida.
Ø Lesão celular letal São representadas pela necrose (morte celular seguida de autólise) e pela apoptose (morte celular não seguida de autólise). • A inflamação é a lesão mais complexa que envolve todos os componentes teciduais.
Necrose Ø É a morte da célula ou parte de um tecido que compõe o organismo vivo. Ø Manifestação final de uma célula que sofreu uma lesão irreversível. Ø Quando param as funções orgânicas e os processos reversíveis do metabolismo.
Causas da necrose Ø Agentes físicos: temperatura, efeitos magnéticos, radiação, entre outros. Ø Agentes químicos: dentro deste grupo estão inclusas substâncias tóxicas e não-tóxicas (álcool, drogas, detergentes entre outros). Ø Agentes biológicos: em casos de infecções virais, bacterianas ou micóticas, parasitas, entre outros. Ø Insuficiência circulatória (necroses isquêmicas): são compreendidas no grupo as necroses dos infartos, das úlceras de decúbito e das vasoconstrições.
Características da necrose Ø Necrose de coagulação: os tecidos apresentam maior firmeza, são de coloração acinzentada, apresentam-se opacos, turvos e secos, com aspecto da albumina coagulada. Há pouca retração e, até o contrário, os tecidos se incham. É causada por isquemia local. Ø Necrose de liquefação: este tipo aparece em tecidos ricos em lipídio e pobres em albuminas coaguláveis. Pode ser observada em abscessos e no sistema nervoso central, assim como em algumas neoplasias malignas.
Ø Necrose caseosa o material necrosado adquire um aspecto de queijo. Esse tipo de necrose aparece na tuberculose, em neoplasias malignas e em alguns tipos de infarto. Ø Necrose gangrenosa: é provocada por isquemia ou pela ação de microrganismos. Pode ser úmida ou seca, dependendo da quantidade de água existente. Exalam um odor pútrido; frequentemente há a formação de bolhas gasosas. Ø Necrose hemorrágica: ocorre quando há a presença de hemorragia no órgão necrosado.
Apoptose Ø Morte celular programada. Ø Tipo de "autodestruição celular" que ocorre de forma ordenada e demanda energia para a sua execução (diferentemente da necrose)
Crescimento Celular Ø Processo essencial para os seres vivos Ø Crescimento celular – multiplicação celular, indispensável durante o desenvolvimento e para reposição celular.
Diferenciação Celular • Especialização morfológica e funcional
Lábeis: Ø Alto potencial mitótico Ø Divisão contínua por toda a vida Ø (Ex. : epitélio de revestimento, hematopoiéticas). células Estáveis: Ø Baixo índice de divisão mitótica Ø Proliferam quando estimuladas Ø (Ex. : órgãos glandulares, células endoteliais). Perenes: Ø Não se dividem após o nascimento Ø (Ex. : neurônios).
Tipos de Distúrbios Celulares Ø Aumento da demanda e estímulos externos – hiperplasia e hipertrofia; Ø Diminuição de nutrientes e fatores de crescimento – atrofia e hipoplasias; Ø Formação incompleta de um órgão ou estrutura – aplasia; Ø Mudança do tipo celular – metaplasias; Ø Estímulos diversos levam a adaptação; Ø Estimulação direta – fatores de crescimento produzidos pelas próprias células ou células vizinhas; Ø Ativação de vários receptores de superfície e vias de sinalização; Ø Indução da síntese de novas proteínas pelas célulasalvo, por aumento na demanda; Ø Estimulação da proliferação, como resposta as influências hormonais;
Neoplasias Ø (neo = novo + plasia = formação) é o termo que designa alterações celulares que acarretam um crescimento exagerado destas células, ou seja, proliferação celular anormal, sem controle. Ø Maligna ou Benigna Ø A célula neoplásica sofre alteração nos seus mecanismos regulatórios de multiplicação, adquire autonomia de crescimento e se torna independente de estímulos fisiológicos
Ø As neoplasias benignas geralmente não são letais e nem causam sérios transtornos ao hospedeiro. Ø As malignas, em geral, tem crescimento rápido, e muitas provocam perturbações homeostáticas graves, acabando por levar o paciente à morte. Ø Os órgãos mais afetados pela metástase são o pulmão, fígado, rim, cérebro e ossos.
Os agentes neoplásicos são divididos em: Ø - Agentes físicos: Energia radiante, energia térmica … Ø - Agentes químicos: Corantes, fumo … Ø - Agentes biológicos: virais, bacterianos …
Inflamação Ø Reação dos tecidos vascularizados a um agente agressor caracterizada morfologicamente pela saída de líquidos e de células do sangue para o interstício. Ø Mecanismo defensivo muito importante contra inúmeras agressões, mas também pode causar danos ao organismo. Ø A inflamação é fundamentalmente uma resposta protetora cujo objetivo final é livrar o organismo da causa inicial da lesão celular (p. ex. , micróbios, toxinas) e das consequências dessa lesão (p. ex. , células e tecidos necróticos).
Ø Sem inflamação, as infecções prosseguiriam desimpedidas, as feridas jamais cicatrizariam e os órgãos danificados poderiam tornar chagas ulceradas permanente. Ø A inflamação aguda tem uma duração relativamente curta, de minutos, várias horas ou alguns dias, e suas principais características são exsudação de líquido e proteínas plasmáticas (edema) e a emigração de leucócitos, predominantemente neutrófilos.
Ø A inflamação crônica tem uma duração mais longa e está associada histologicamente á presença de linfócitos e macrófagos, proliferação de vasos sanguíneos, fibrose e necrose tecidual. Sintomas típicos da inflamação Ø calor; Ø rubor (cor avermelhada); Ø tumor (ferida); Ø dor.
A inflamação é subdivida em diferentes fases, são elas: Ø Alteração do calibre e fluxo vascular: que gera calor e vermelhidão; Ø Permeabilidade vascular aumentada: que gera o inchaço; Ø Migração de leucócitos: chegada das células de defesa; Ø Quimiotaxia e fagocitose: combate aos agentes agressores, que pode levar à cura ou gerar uma inflamação crônica dependendo do caso.
Distúrbios Hemodinâmicos Ø Referem-se ás alterações circulatórias que acometem a irrigação sanguínea e o equilíbrio hídrico. Ø são manifestações muito comuns na clínica médica, podendo muitas vezes ser a principal causa de morte. Ø Quando há um rompimento desse equilíbrio, surgem alterações que comumente podem ser agrupadas dentro dos distúrbios circulatórios, que se classificam em alterações hídricas intersticiais (edema), alterações no volume sanguíneo (hiperemia, hemorragia e choque) e alterações por obstrução intravascular (embolia, trombose, isquemia e infarto).
Edema Ø Acúmulo anormal de líquido nos espaços intersticiais ou em cavidades corporais. Ø Pode ocorrer como um processo localizado, como por exemplo, quando o retorno venoso de uma perna é obstruído, ou pode ser sistêmico na distribuição, como por exemplo, na insuficiência renal.
Classificação do Edema Ø Transudato: corresponde aos líquidos de edema não-inflamatório, são pobres em proteínas, apresentam uma aparência clara e serosa, há uma preservação da membrana vascular. Ø Exsudato representa o edema inflamatório relacionado com o aumento da permeabilidade endotelial que é rico em proteínas, é produzido pela evasão de proteínas plasmáticas (principalmente albumina) e, possivelmente, leucócitos.
Ø edema localizado: quando o acúmulo de líquido ocorre em regiões determinadas, como por exemplo, no cérebro, pulmões e membros inferiores. Ø edema generalizado: quando o acúmulo de líquido ocorre em todos ou em vários tecidos do corpo.
Exemplo de coleção de líquido chamado transudato, ocasionado por uma pequena queimadura.
Edema localizado
Ø O edema de distribuição denominado “anasarca”. generalizada é Ø A anasarca é caracterizada pelo excesso generalizado de líquido no interstício e no interior das próprias células. Ø O termo técnico anasarca significa edema (acúmulo de líquidos) generalizado no corpo.
Hemorragia Ø Extravasamento de sangue devido á ruptura do vaso para um compartimento extra vascular ou para fora do organismo Ø A ruptura de uma grande artéria ou veia é quase sempre devida á lesão vascular, incluindo trauma, aterosclerose ou lesão inflamatória ou neoplásica da parede do vaso. Ø A hemorragia pode ser manifestada em uma variedade de padrões dependendo do tamanho, extensão e da localização do sangramento.
Classificação da Hemorragia Ø Origem (capilar, venosa ou arterial); Ø Visibilidade (externa, quando o sangue é visível, ou interna, quando o sangue não é visível). Ø Volume (petéquias = pequenas manchas; equimoses = áreas mais extensas; hematoma = coleção de sangue, em geral coagulado; púrpura = empregado para hemorragias espontâneas; apoplexia = fusão intensa na região cerebral).
Trombose • É um distúrbio vascular causado pela formação de um coágulo de sangue (trombo) dentro de um vaso sanguíneo (veia ou artéria), impedindo ou interrompendo o fluxo de sangue. • Esses trombos podem obstruir a circulação no local ou, na pior hipótese, atingir os pulmões, bloqueando a oxigenação do sangue (embolia pulmonar). • Alguns fatores como hipertensão, obesidade, sedentarismo, tabagismo, imobilização prolongada, gravidez, estresse, diabetes, traumatismos, certos procedimentos cirúrgicos ou uso de pílulas anticoncepcionais podem promover processos trombóticos vasculares.
Tipos de trombose: • Trombose venosa: Ø É causada por um coágulo de sangue que se desenvolve em uma veia. Ø Pode ser o resultado de doenças ou lesões nas veias das pernas, imobilidade por qualquer motivo, fratura, certos medicamentos, obesidade, doenças hereditárias ou predisposição hereditária. Ø Existem várias doenças que podem ser classificados nesta categoria. Podemos destacar a trombose venosa profunda que é uma doença relativamente comum. Ø Ela ocorre em 90% dos membros inferiores com maior frequência para a perna esquerda e os 10% restante afeta os membros superiores, pelves, cavidade abdominal, torácica, cabeça e pescoço.
• Trombose arterial Ø É causada por um coágulo de sangue que se desenvolve em uma artéria. Ø Quando a trombose arterial ocorre nas artérias coronárias pode causar um ataque cardíaco no indivíduo. Ø Quando isso acontece na circulação cerebral, pode causar acidente vascular cerebral ou falta de oxigênio para outros órgãos.
Ø Muitas vezes a trombose desenvolve pouco ou quase nenhum sintoma no indivíduo. Ø É muitas vezes referida como uma doença silenciosa. Ø As veias das pernas são mais comumente atingidas pela trombose. Ø Sintomas como dor intensa, inchaço na perna, vermelhidão, calor no local, endurecimento da musculatura da perna e formação de nódulos dolorosos nas varizes, são frequentes.
Ø O tratamento específico de trombose será determinado pelo médico com base na idade e saúde geral do paciente, a extensão e o tipo de trombose, bem como sua tolerância para medicamentos, procedimentos ou terapias. Ø O tratamento pode incluir medicamentos anticoagulantes como a heparina, cateteres, entre outros.
Para evitar a trombose recomenda-se: Ø Não fumar Ø Manter o peso equilibrado e dentro do IMC. Ø Após algum tipo de cirurgia é conveniente colocar o corpo em movimento. Ø Diabéticos e hipertensos devem seguir uma dieta rigorosa e não parar a medicação. Ø Praticar regularmente exercícios físicos. Ø Mulheres cuja idade seja superior a 35 anos, devem tomar cuidado com o uso de pílulas anticoncepcionais.
Infarto Ø Área de necrose tecidual isquêmica causada por uma obstrução do suprimento arterial ou da drenagem venosa num tecido particular Ø O infarto pode ser causado por oclusão arterial (devido a eventos trombóticos ou embólicos), vasoespasmo local, expansão de um ateroma devido à hemorragia dentro de uma placa ou compressão intrínseca de um vaso (p. ex. : tumor).
Os infartos são classificados, quantidade de hemorragia refletindo a Ø Vermelhos (hemorrágicos) Ø Brancos (isquêmicos) • Hemorrágico: Sua causa principal é sempre arterial devido a uma oclusão tromboembólica, compressiva. • Ocorre com oclusões arteriais em órgãos sólidos de circulação arterial terminal (p. ex. : coração, pâncreas e rim).
Choque Ø O choque ou colapso cardiovascular é a incapacidade do sistema circulatório em reperfundir (restabelecer a circulação na isquemia para evitar infarto) os tecidos, gerando uma hipotensão.
Classificação do choque Ø Cardiogênico: resulta da perda sanguínea ou volume plasmático, devido a uma hemorragia, perda líquida por queimaduras graves ou trauma. Está relacionado com o infarto do miocárdio. Ø Hipovolêmico: condição onde o coração é incapaz de fornecer sangue suficiente para o corpo devido à hemorragia e falta de nutrientes aos órgãos, também pode ser causado pela liberação de toxinas no trato gastrointestinal pela Vibrio cholerae (causando diarreia e desidratação).
Ø Séptico: causado por infecção bacteriana sistêmica, geralmente por administração inadequada de anestésicos ou lesão da medula espinhal; Ø - Anafilático: é iniciado por uma reação de hipersensibilidade tipo 1 (mediada por Ig. E), associa-se com vasodilatação sistêmica e permeabilidade vascular aumentada; Ø - Neurogênico: responsável em provocar lesão cerebral e na medula espinhal.
Estágios do choque Ø Fase reversível: durante a qual os mecanismos compensatórios (p. ex. : sistema reninaangiotensina) reflexos são ativados e a perfusão dos órgãos vitais é mantida; Ø - Fase progressiva: caracterizada por uma hipoperfusão tecidual e início da piora circulatória e desequilíbrios metabólicos incluindo acidose; Ø - Fase irreversível: estabelece-se após o corpo ter causado a si próprio lesão celular e tecidual tão grave que mesmo se os defeitos hemodinâmicos fossem corrigidos, a sobrevivência não seria possível.
Distúrbios Metabólicos Ø Vários tipos de alterações a nível celular em que há perturbação ou redução do metabolismo. Ø Acúmulo de substâncias intracelulares ou extracelulares. Ø Quando muito graves, levam à morte celular ou necrose.
Distúrbios do Metabolismo dos Carboidratos Ø Os carboidratos são açúcares. Ø Muitos açúcares, além dos bem conhecidos glicose, sacarose e frutose, estão presentes nos alimentos. Ø Alguns açúcares (p. ex. , sacarose) devem ser metabolizados (processados) por enzimas no organismo antes de serem utilizados como fonte de energia. Ø Quando as enzimas necessárias para o seu processamento estão ausentes, pode ocorrer um acúmulo desses açúcares, acarretando problemas.
Ø Um em cada 50. 000 a 70. 000 recém-nascidos nasce sem essa enzima. Ø A princípio, o recém-nascido parece normal, mas, após alguns dias ou semanas, ele apresenta inapetência, vômito, icterícia e para de crescer normalmente. Ø Ele apresenta o fígado aumentado de tamanho, presença excessiva de proteínas e aminoácidos na urina, edema dos tecidos e retenção líquida. Ø Quando o tratamento é iniciado tardiamente, as crianças afetadas apresentam uma estatura baixa e retardo mental. Ø Muitas apresentam catarata. Na maioria dos casos, a causa desses sintomas é desconhecida.
Doenças de armazenamento de glicogênio (glicogenoses): Ø Constituem um grupo de distúrbios hereditários causados pela ausência de uma ou mais das muitas enzimas necessárias para converter o açúcar (glicose) em sua forma de armazenamento, o glicogênio, ou para convertê-lo de volta em glicose e ser utilizado como energia. Ø Nas doenças do armazenamento de glicogênio, ocorrem depósitos de tipos ou quantidades anormais de glicogênio nos tecidos do organismo, principalmente no fígado.
Ø As doenças do armazenamento de glicogênio tendem a provocar o acúmulo de ácido úrico, um produto metabólico, podendo causar a gota e a formação de cálculos renais. Ø Frequentemente, o tratamento medicamentoso é necessário para prevenir que isto ocorra. Ø Em alguns tipos de doença do armazenamento de glicogênio, a quantidade de exercícios realizados pela criança deve ser limitada para reduzir as câimbras musculares.
Distúrbios do Metabolismo do Piruvato Ø O piruvato é formado no metabolismo dos carboidratos, gorduras e proteínas. Ø Os problemas hereditários relacionados ao metabolismo do piruvato podem causar uma ampla variedade de distúrbios. Ø O piruvato é uma fonte de energia para as mitocôndrias, componente celulares gerador de energia.
Ø Um problema relacionado ao metabolismo do piruvato pode comprometer o funcionamento das mitocôndrias, causando qualquer um dos vários sintomas possíveis, como, por exemplo, lesão muscular, retardo mental, convulsões, acúmulo de ácido lático que acarreta acidose (excesso de ácido no organismo) ou falhas no funcionamento de um órgão (p. ex. , coração, pulmões, rins ou fígado). Ø Esses problemas podem ocorrer em qualquer época, desde a primeira infância até a vida adulta. O exercício, as infecções ou o consumo de álcool podem piorar os sintomas, causando uma acidose lática grave acompanhada de câimbras e fraqueza muscular.
Ø Os principais sintomas incluem a atividade muscular lenta, a má coordenação e um grave distúrbio do equilíbrio que praticamente impossibilita a marcha. Ø Além disso, a pessoa pode apresentar convulsões, retardo mental e malformação cerebral. Ø Este distúrbio não tem cura, mas algumas pessoas são beneficiadas com uma dieta rica em gordura.
Distúrbios do Metabolismo dos Aminoácidos Ø Os aminoácidos, as unidades formadoras das proteínas, desempenham várias funções no organismo. Ø Os distúrbios hereditários do metabolismo dos aminoácidos podem ser defeitos na degradação dos aminoácidos ou no seu transporte para o interior das células. Ø Já foram identificados muitos desses distúrbios, incluindo a fenilcetonúria. Ø Em todos os estados Estados Unidos, os recém-nascidos são submetidos à investigação da fenilcetonúria e também de outros distúrbios metabólicos.
Ø A fenilcetonúria (FCU, fenilalaninemia, oligofrenia fenilpirúvica) é um distúrbio hereditário no qual a enzima que processa o aminoácido fenilalanina está ausente, acarretando em uma concentração perigosamente alta de fenilalanina no sangue. Ø Normalmente, a fenilalanina é convertida em tirosina, um outro aminoácido, e eliminada do organismo. Sem a enzima que a converte, a fenilalanina acumula-se no organismo e é tóxica para o cérebro, causando retardo mental.
Ø Os sintomas da fenilcetonúria geralmente estão ausentes nos recém-nascidos. Ø Em raros casos, o recém-nascido apresenta sonolência ou alimenta-se pouco. Ø As crianças com fenilcetonúria tendem a ter a pele, o cabelo e os olhos mais claros que os membros da família que não a apresentam.
Ø O Diabetes Melitus é um Distúrbio causado pela falta absoluta ou relativa de insulina no organismo. Ø Quando a insulina produzida pelo pâncreas se torna insuficiente, a glicose é impedida de ser absorvida pelas células, o que provoca a elevação dos níveis sanguíneos de glicose, cuja taxa normal, em jejum, é de 70 a 100 mg por 100 ml de sangue.
Diabetes tipo 1: Ø O pâncreas não produz insulina. Quando pouca ou nenhuma insulina vem do pâncreas, o corpo não consegue absorver a glicose do sangue, assim o nível de glicose no sangue fica constantemente alto. Ø A dieta correta e o tratamento com insulina são necessários por toda a vida de um diabético.
Diabetes tipo 2: Ø É o tipo de diabetes mais comum, ocorre mais em adultos. Ø Pode ser controlado somente com dieta ou, a dieta com o comprimido hipoglicemiante oral. Ø O fator hereditário neste caso tem uma importância bem maior que no Diabetes tipo 1. Ø Este tipo de diabetes afeta 10% da população adulta. Ø Neste caso a insulina é produzida, porém sua ação não é eficaz.
Ø Os sintomas do Diabetes tipo 2 são menos perceptíveis, sendo esta a razão para considerálo mais “silencioso” que o tipo 1. Ø Seus sintomas podem permanecer despercebidos por muito tempo, pondo em sério risco a saúde do indivíduo.
SUSPEITAS DE DIABETES Ø urinar muitas vezes em grande quantidade; Ø sede exagerada; Ø obesidade; Ø perda de peso; Ø ter muita fome.
Diagnóstico: Ø O exame a ser feito é a dosagem de glicose no sangue (GLICEMIA) e na urina (GLICOSÚRIA). CONSEQÜÊNCIAS DO DIABETES NÃO CONTROLADO: Ø Cegueira; Ø Infarto do Miocárdio; Ø Gangrena; Ø Impotência sexual masculina; Ø Outras complicações como hipertensão arterial (pressão alta), insuficiência renal e infecções.
Patologia Cardíaca Ø São doenças que afetam o sistema circulatório, ou seja, os vasos sanguíneos e o coração. Ø Existem vários tipos de doenças cardiovasculares (infarto do miocárdio, arritmia). Ø Entre as mais comuns podemos referir o enfarte do miocárdio, a angina de peito, a aterosclerose, entre outras. ØA principal característica das doenças cardiovasculares é a presença da aterosclerose, acúmulo de placas de gorduras nas artérias ao longo dos anos que impede a passagem do sangue.
Ø Para funcionar, o corpo humano precisa de oxigênio. Ø O sangue sai do coração com oxigênio e atinge todos os órgãos por meio das artérias; depois, volta ao coração para se reabastecer de oxigênio. Ø Quando as artérias fecham (aterosclerose), ocorre um infarto na região que não recebeu o oxigênio. Ø Basta não receber oxigênio, para região entrar em colapso
Ø Os hábitos de vida adotados por grande parte da população, como o sedentarismo, a falta de atividade física diária, uma alimentação desequilibrada ou o tabagismo, constituem hoje fatores de risco. Ø Os riscos de um acidente vascular cerebral ou do desenvolvimento de outra doença cardiovascular aumentam com o excesso de peso, mesmo na ausência de outros fatores de risco. Ø Para ser saudável, a alimentação deve ser variada e polifracionada (muitas refeições ao longo do dia).
Fatores de risco Ø Hipercolesterolemia Ø Hipertensão Arterial: A hipertensão arterial está associada a um maior risco de doenças cardiovasculares, particularmente o acidente vascular cerebral. Ø Stress excessivo: É possível reduzir o risco de doenças cardiovasculares através da adopção de um estilo de vida mais saudável.
Aterosclerose: Ø Presença de certos depósitos na parede das artérias, incluindo substâncias gordas, como o colesterol e outros elementos que são transportados pela corrente sanguínea. Ø A aterosclerose afeta artérias de grande e médio calibre, sendo a causa dos Acidentes Vasculares Cerebrais e da Doença das Artérias Coronárias. Ø É uma doença lenta e progressiva e pode iniciar-se ainda durante a infância. Ø Contudo, regra geral, não causa qualquer sintomatologia até aos 50/70 anos, embora possa atingir adultos jovens (30/40 anos), principalmente se forem fumadores intensivos;
Cardiopatia Isquêmica: Ø Termo utilizado para descrever as doenças cardíacas provocadas por depósitos ateroscleróticos que conduzem à redução do Lúmen das artérias coronárias. Ø O estreitamento pode causar Angina de Peito ou Infarto do Miocárdio, se em vez de redução do Lúmen arterial se verificar obstrução total do vaso;
Doença Arterial Coronária: Ø Situação clínica em que existe estreitamento do calibre das artérias coronárias, provocando uma redução do fluxo sanguíneo no músculo cardíaco. Ø As doenças cardíacas são agudas ou crônicas. Ø Podem ser transitórias, relativamente estáveis ou progressivas.
Ø Os sinais e sintomas com frequência se alteram ou pioram com o tempo. Ø Doenças cardíacas crônicas podem apresentar exacerbações, remissões espontâneas ou com tratamento, ou piora progressiva. Ø São comuns sintomas vagos no início das doenças, como fadiga, falta de ar com ou sem esforço, tonteiras ou náuseas.
As complicações desse tipo de doença incluem: Ø Arritmias - Alterações do ritmo cardíaco. Ø Dilatação – Aumento de volume de uma ou mais câmaras cardíacas por elevação da pressão interna. Ø Hipertrofia – Aumento da espessura das paredes, resultando em diminuição do volume das câmaras e perda de flexibilidade do coração. Ø Contração insuficiente – Dificuldade de enchimento e esvaziamento das câmaras.
Ø Estenose – Estreitamento de valvas cardíacas. Ø Regurgitação – Fechamento incompleto de valvas, causando refluxo e aumento da pressão na circulação pulmonar ou no sistema venoso periférico. Ø Isquemia – Falta de oxigênio no coração provocada por redução do fluxo das artérias coronárias. Causa dor, que pode ocorrer com esforços ou em repouso. Ø Infarto – Morte de células musculares cardíacas devido à isquemia. O tecido muscular morto é substituído por tecido fibroso.
Tratamento Ø Doenças agudas, como infarto do miocárdio, exigem tratamento médico imediato para minimizar lesões. Ø No caso de doenças crônicas, o médico pode recomendar mudanças na dieta, perda de peso excessivo, exercícios sob supervisão, controle do estresse e suspensão do fumo.
Patologia Pulmonar Ø Hoje em dia, com o evoluir da industrialização e consequente aumento da poluição atmosférica surge um numero cada vez maior de doenças respiratórias. Ø Os pulmões são parte do sistema respiratório e se localizam no tórax, dentro da caixa torácica e acima do diafragma. Ø Tem a função de absorver oxigênio e eliminar dióxido de carbono.
Ø Os pulmões contêm um sistema de defesa, incluindo células imunológicas e muco, que nos protege de muitos componentes nocivos do ar, como: Ø poeira, Ø polens, Ø bactérias, Ø vírus, Ø Fumaça, etc.
Asma: Ø É uma doença pulmonar crônica caracterizada por inflamação dos brônquios e dos bronquíolos e crises de obstrução das vias aéreas. Ø As crises podem ser desencadeadas por fumaça de cigarro ou outras partículas no ar, poeira, mofo, alergênicos, exercícios, ar frio e outras causas. Ø Durante a crise, o revestimento das vias aéreas se espessa e os músculos brônquicos se contraem, dificultando a passagem do ar.
Ø A secreção de muco prejudica mais ainda o fluxo, tornando a respiração difícil e gerando sibilos. Ø A maioria das crises não causam lesão pulmonar permanente, mas com frequência precisa de atenção médica imediata, porque a falta de oxigênio e o acúmulo de dióxido de carbono podem por a vida em risco.
Infecções: Ø Podem afetar principalmente todo o corpo, incluindo os pulmões, ou se desenvolver na pleura, membrana que envolve os pulmões. Ø Podem ser agudas ou crônicas, e ser causadas por bactérias, vírus ou, mais raramente, fungos. Ø Pneumonia é uma inflamação pulmonar aguda provocada por diversos micro-organismos.
Fibrose cística: Ø É uma doença hereditária que afeta os pulmões, o pâncreas e outros órgãos. Ø O suor é salgado e é produzido um muco espesso que dificulta a respiração e a secreção pancreática, prejudicando a absorção de alimentos e causando desnutrição.
Ø Os sinais e sintomas associados a doenças pulmonares variam entre pessoas e com o tempo. Ø Inclui: tosse persistente e dispneia, sibilos, respiração ofegante, tosse com sangue ou escarro, e dor torácica. Ø A falta de oxigênio no sangue pode dar uma coloração azulada à pele. Ø Algumas pessoas podem mostrar baqueteamento de dedos, alargamento das pontas dos dedos e das unhas.
Diagnóstico Ø Gasometria arterial - Uma amostra de sangue arterial é colhida para avaliar o p. H, o oxigênio e o dióxido de carbono. Ø Hemograma - Para pesquisar anemia Ø Pesquisa e cultura de bacilos álcool-ácido resistentes – Para diagnosticar tuberculose e micobacterioses atípicas Ø Hemocultura – Para diagnosticar disseminação no sangue de infecções por bactérias ou fungos.
Ø Influenza – Para diagnóstico de gripe. Ø Biópsia pulmonar – Para avaliar lesões e pesquisar câncer de pulmão. Ø Citologia do escarro – Para pesquisar alterações e células cancerosas. Ø Testes de maturidade pulmonar fetal – São usados para verificar a maturidade fetal e o risco de sofrimento respiratório do recém-nascido antes de um parto cesariano ou um trabalho de parto prematuro. Ø Dosagens de drogas – Para avaliar abuso de drogas, que pode causar sofrimento respiratório em adultos.
Ø A DPOC é uma doença respiratória crónica e progressiva que vai roubando, pouco a pouco, a capacidade de respirar. Ø A partir dos 40 anos, fumantes e ex-fumantes entram no grupo de risco desta doença, mas muitos ignoram os sintomas e não fazem o rastreio. Ø Caracterizada por falta de ar (dispneia), tosse e aumento da produção de expectoração, impede as pessoas de realizarem tarefas diárias banais como, por exemplo, conduzir ou subir escadas, fazer a cama ou vestirem-se. Ø Com a progressão da doença a falta de ar manifesta-se até durante os períodos de descanso.